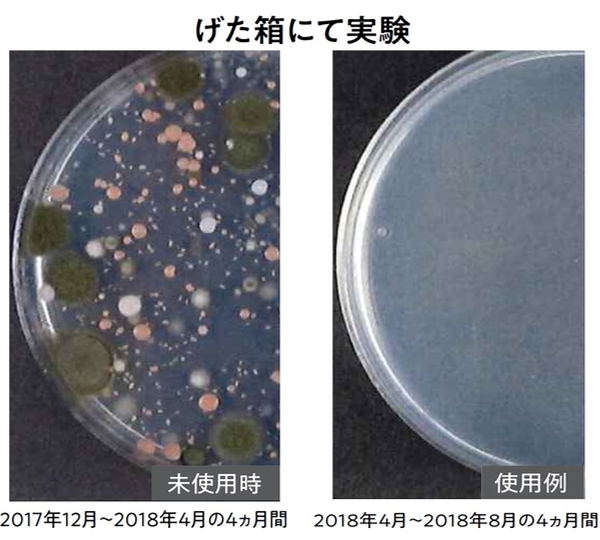

防カビ剤 パワーバイオ 玄関 下駄箱 カビ 予防 消臭 ( げた箱 靴箱 防カビ 防臭 におい 貼る カビ対策 カビ防止 抗カビ 臭い ニオイ 抗菌 効果 微生物 臭い取り )
Pontaパス特典
サンキュー配送
748円(税込)
0ポイント(1%)
お店で開催中のキャンペーン
レビュー投稿でポイントプレゼント!
商品説明

下駄箱に貼るだけで臭い・カビを抑える
●湿気が溜まりやすい下駄箱のカビ・臭いを抑えます。
●下駄箱の天井に貼るだけの簡単設置タイプです。
●効果は約4ヶ月間です。
●バイオシリーズは微生物が空気中で活動し、カビや臭いを抑制するよう開発されました。
おすすめポイント

下駄箱の臭い・カビを抑える
微生物の働きを利用して、下駄箱の気になる臭い・カビを抑えます。効果目安は約4ヶ月間です。約幅80×奥行40×高さ100cmの下駄箱に1個設置してください。

簡単設置が可能
下駄箱の天井に貼るだけで簡単に設置して頂く事ができます。
商品詳細


バイオとは
バイオとは肉眼で見ることができない微生物です。地球上の土、水、植物、空気をはじめ、あらゆるところで生きて活動しています。バイオは空気に触れて活動を始めると、抗菌物質を発生してカビの繁殖を抑えます。人にも環境にも優しいパワーバイオシリーズは、化学薬品を使用せず微生物の働きを利用して、従来品よりもカビ・臭いを抑制するよう開発されたお掃除アイテムです。
シリーズ紹介
 玄関・下駄箱 |  キッチン・シンク下 |  お風呂・排水口 |
 トイレ |  キッチン・排水口 |  お風呂 |
 押入れ |  エアコン |  窓まわり |
 ゴミ箱 |
| サイズ | 約 幅6.8×奥行1.7×高さ4.8(cm) |
| 内容量 | 1個 |
| 材質 | 中身:珪藻土、微生物(バチルス菌属) ケース:ポリプロピレン |
| 生産国 | 日本製 |
| 備考 | 交換目安:約4ヶ月 約幅80×奥行40×高さ100cmの下駄箱に1個設置してください。 |
| 区分 | 返品・キャンセル区分(小型商品) |
| ギフト | ラッピングページを見る |



CODE/370886
関連キーワード
下駄箱に貼るだけで臭い・カビを抑える
《 LH7198 抑える 天然素材 安全 安心 掃除グッズ そうじグッズ そうじ道具 そうじ用品 便利グッズ 手軽 コンパクト 日本製 シューズクローゼット シューズボックス 》
《 LH7198 抑える 天然素材 安全 安心 掃除グッズ そうじグッズ そうじ道具 そうじ用品 便利グッズ 手軽 コンパクト 日本製 シューズクローゼット シューズボックス 》
レビュー
商品の評価:



 -点(0件)
-点(0件)





















